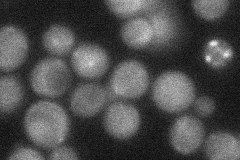
YMR211W

View description
Essential protein involved in mtDNA inheritance, may also function in the partitioning of the mitochondrial organelle or in the segregation of chromosomes, exhibits regions similar to members of a GTPase family
Localization:
Intensity:
Fold change:
Significance:
-
C’ GFP library in SD

below threshold17.8 -
N' NOP1pr-GFP in SD

cytosol87.6928 -
N' TEF2pr-mCherry in SD

cytosol62.522 -
N' NATIVEpr-GFP in SD
cytosol31.1033 -
N' TEF2pr-VC and Cyto-VN in SD

#N/A0 -
C’ GFP library in SD+DTT

cytosol20.681.16No -
C’ GFP library in SD+H2O2

cytosol18.341.03No -
C’ GFP library in Starvation Media

cytosol18.691.04No -
C’ GFP library on the background of Pup2-DaMP

below threshold -
C’ GFP library on the background of CCT mutant

below threshold21.97631.23428No
